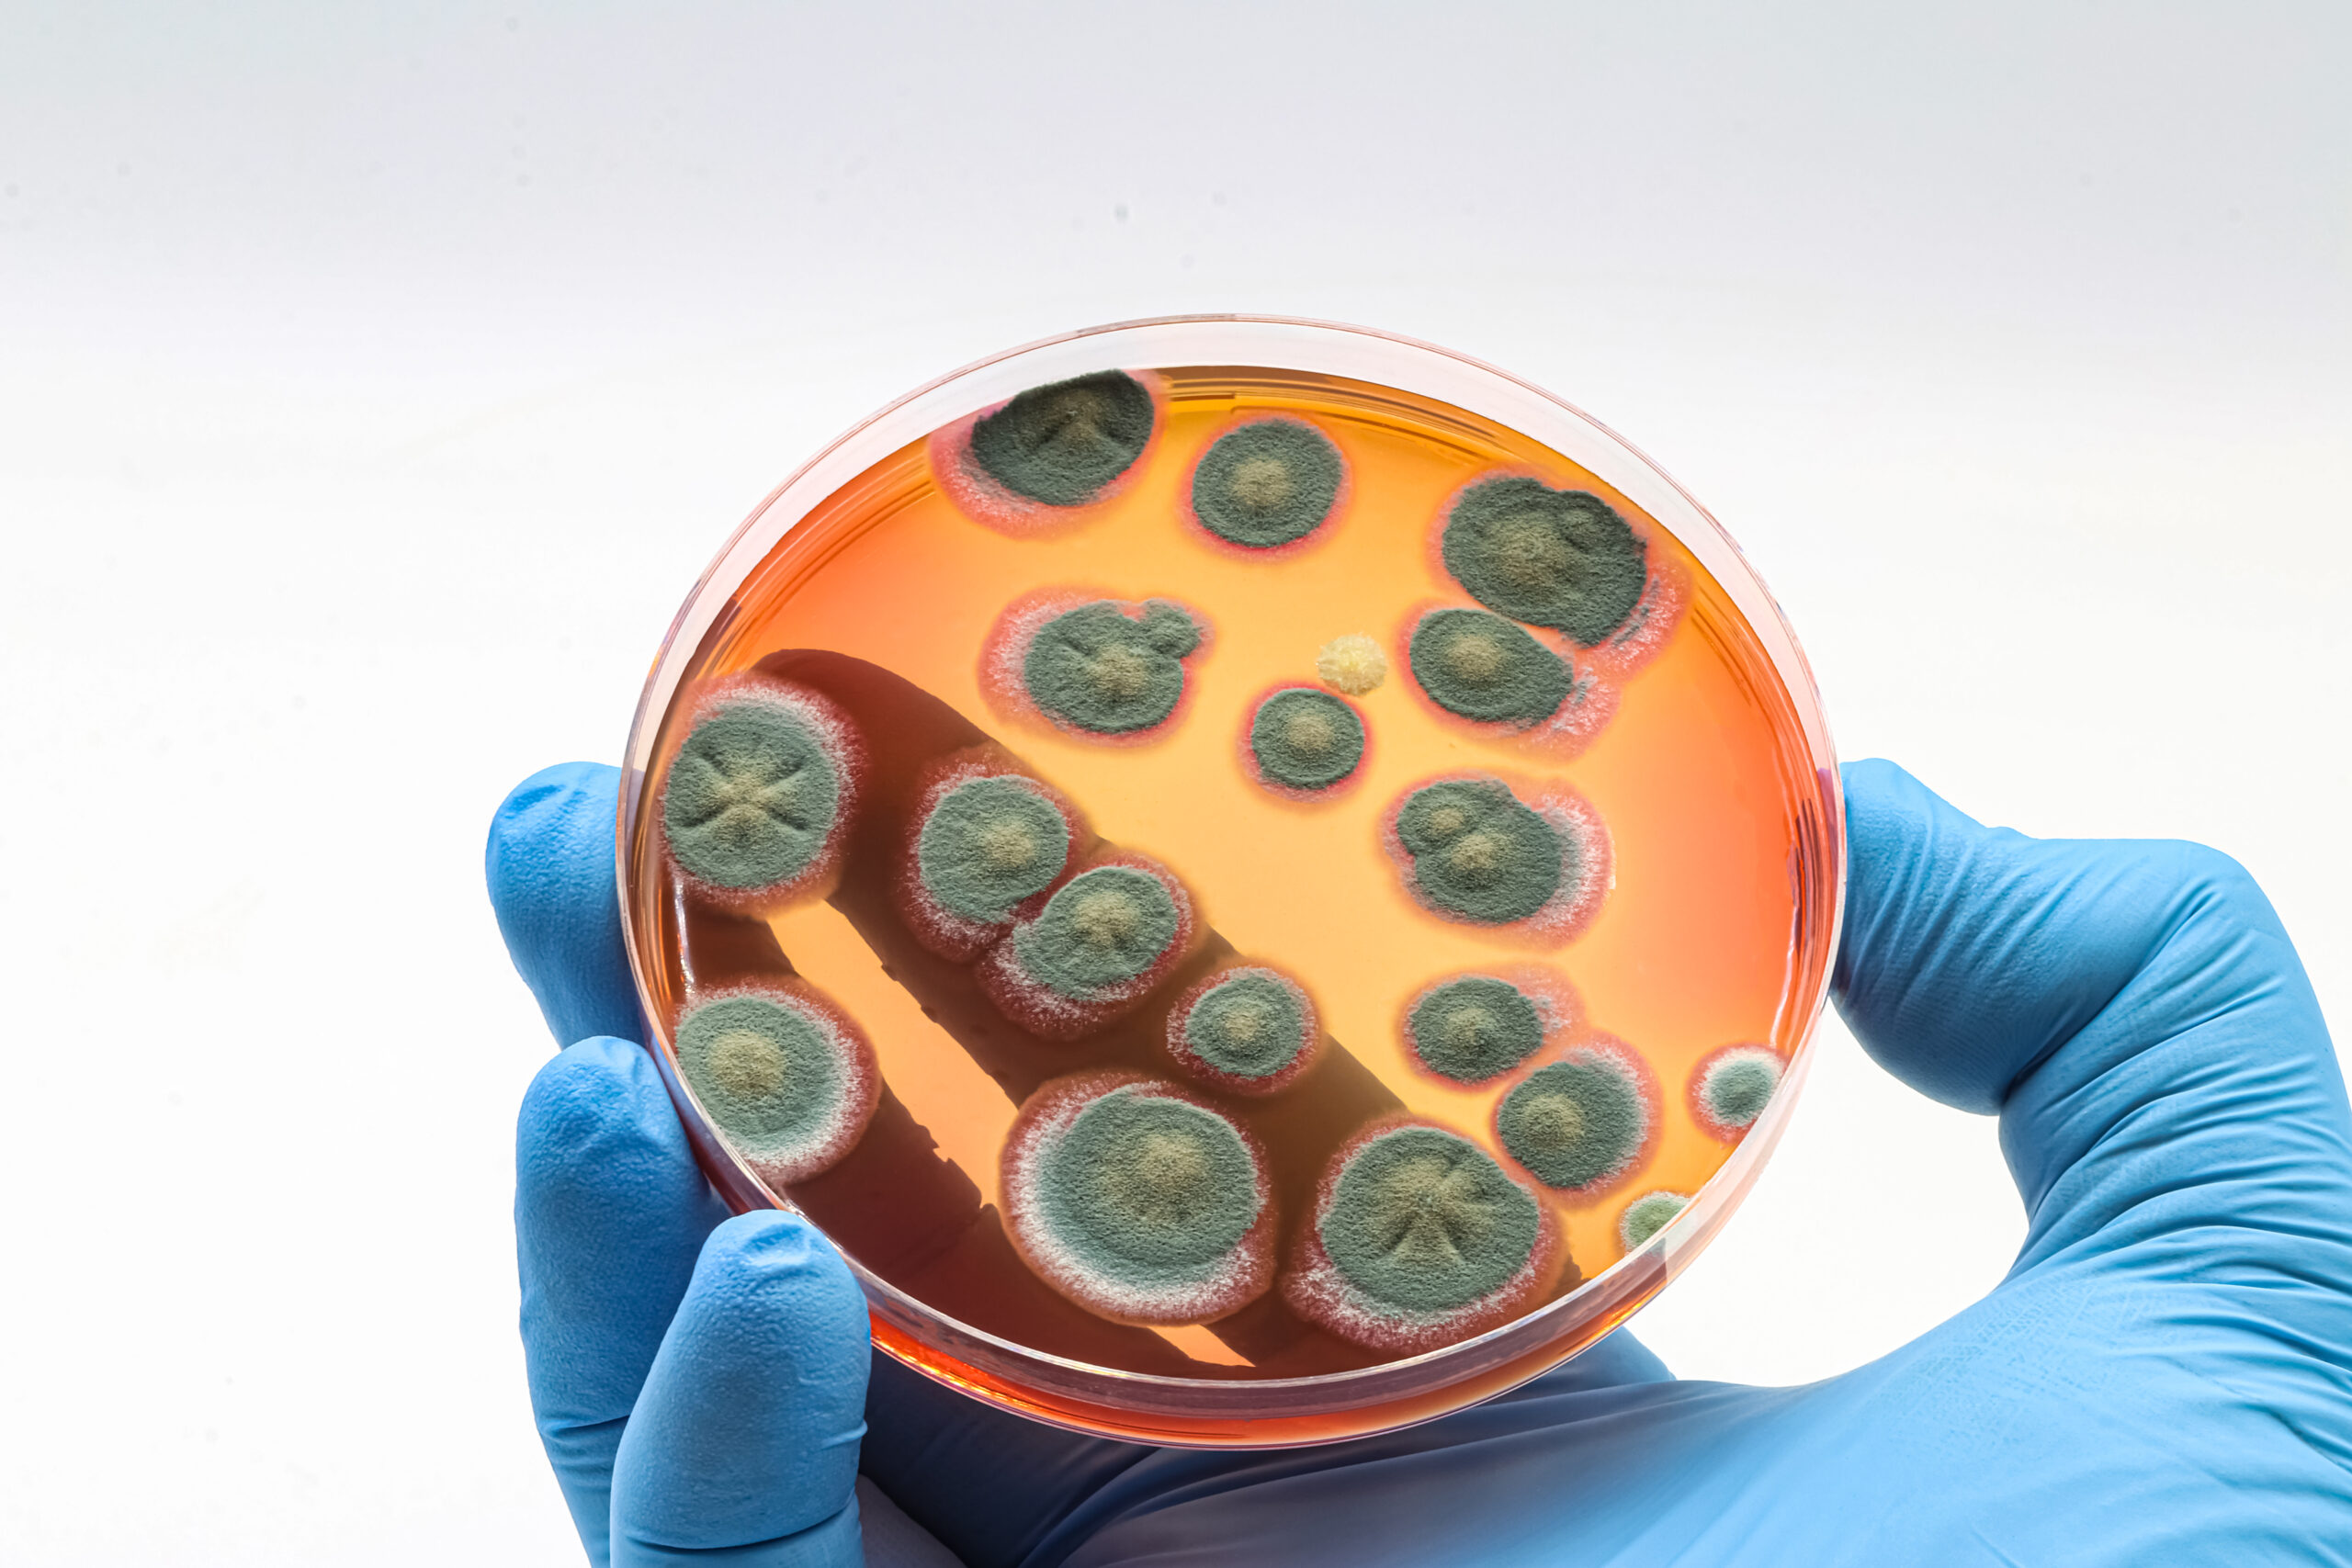
Microbiological culture with a colonies of Fungi, mold.

If you are a homeowner or manage a property, there’s a good chance mold is sitting with you like an uninvited guest. The reports show that nearly half of U.S. homes (47%) show visible signs of mold or carry that musty odor, including school buildings or hospitals. That means it’s not just the thing of old basements or poorly kept houses, but it’s breathing down your neck.
In 2025, people are getting Savvier about indoor air. Mold inspections, making the shift from a precaution because of increasing health risks to something every homeowner, landlord, and facility manager should be paying attention to.
New tools with tech, stricter building codes, and rising awareness of indoor air quality are reshaping how mold is treated because everyone now wants their indoor air to be healthy.
What’s changing most is speed and accuracy. Inspectors today can see through the walls, track moisture before it spreads, and even stop problems before they start.
The State of Mold in U.S. Homes
Mold is more common than most people realize. An ANSI industry survey in 2024 found that nearly one out of every two homes in America is dealing with a mold issue in some way or another.
The problem isn’t going away on its own. According to market research, the mold and moisture assessment industry was valued at just over $2.1 billion in 2023. And by 2032, it’s expected to grow to $3.8 billion.
That’s huge, and it is a sign of just how seriously homeowners, insurers, and regulators are starting to take the issue.
Now you might be thinking, what is the reason for the spike?
Here are some of the factors that include:
- Growing awareness of indoor air quality and its impact on long-term health.
- Stricter building codes aimed at reducing hidden moisture problems.
- More severe weather events leave homes water-damaged and vulnerable.
Since we all love our health and want the same for our loved ones, this side of the story cannot be tolerated or ignored.
Mold exposure has been linked to asthma, allergy symptoms, respiratory irritation, and, in severe cases, chronic illness. Families with children, seniors, or anyone with a weakened immune system are particularly at risk.
For them, even low-level mold exposure can cause daily discomfort, and that makes early detection far more than a maintenance issue.
In other words, mold inspections are no longer something you should schedule only after spotting visible growth or smelling an odor.
But in 2025, they’re becoming part of routine property care, which is a proactive step to protect both the home and the people living in it.
New Tools Shaping Mold Inspections in 2025
What image comes to your mind when you read these two words, “Mold Inspection?” If you are still imagining that a mold inspection is someone walking around with a flashlight and a clipboard, that image is already outdated and belongs to old school stuff.
The industry has emerged into a new era where advanced technology does the heavy lifting, which means giving inspectors sharper tools and homeowners faster answers with the following:
Thermal imaging cameras now allow professionals to see behind walls without tearing anything open. Measuring the subtle temperature differences reveals hidden moisture pockets that are the perfect breeding ground for mold, and it’s best to address them long before the damage spreads. It is so reliable for a trained inspector to scan a basement wall in minutes and detect leaks that might otherwise stay hidden for months.
Moisture meters have also become far more precise. These handheld devices measure the actual water content inside materials like wood, drywall, or concrete. That means inspectors can catch damp areas immediately after storms, plumbing mishaps, or even small roof leaks before they turn into larger mold problems.
Continuous air sensors represent another leap forward. Instead of taking a single air sample and waiting days for lab results, these devices track indoor conditions in real time, flagging sudden changes in humidity, spores, or volatile compounds tied to mold. This kind of constant monitoring is a game-changer for property managers who are juggling multiple buildings.
The results of this inspection are quicker, less invasive, and far more reliable. Simply put, this technology has moved mold inspections from a service into a science where early warnings can save families thousands in repair costs and months of disruption.
How Building Codes and Insurance Are Driving More Inspections
The thing belongs to the past when homeowners only called in a mold inspector when the smell got too strong or black/green spots started creeping across the drywall. But in 2025, inspections are no longer just about reacting, but they’re being built into the rules that shape how we live and ensure our homes.
Stricter building codes are a major driver. Cities and states are updating construction standards to require tighter moisture control in new buildings, from better ventilation systems to mandatory water-damage checks during inspections. Because the idea is simple: safer buildings mean fewer health complaints and fewer expensive lawsuits down the road.
Insurance companies are following suit. Most standard home-insurance policies still exclude mold damage caused by slow leaks or long-term neglect. That leaves homeowners footing the bill unless they can prove the problem was discovered quickly and properly addressed. As a result, many insurers now encourage or even require regular mold assessments before offering full coverage.
Take one scenario: a small leak in a second-story bathroom goes unnoticed for months. By the time the homeowner notices and calls their insurer, mold has spread through the ceiling and into the walls below. Without proof of regular inspection, coverage is likely denied, leaving the homeowner with a bill in the tens of thousands.
For families and property managers, that means mold inspections are becoming a baseline expectation: part of keeping your home compliant, your insurance valid, and your indoor air safe to breathe.
Smart Sensors and Connected Systems: Mold Prevention Goes High-Tech
One of the biggest shifts is not just how we detect mold, but how we prevent it. Thanks to smart home technology, mold inspections are starting to blend with live monitoring.
Smart sensors now track humidity, temperature, and even certain mold-related compounds in the air.
Instead of waiting for a musty odor, these devices send alerts straight to your phone the moment conditions cross into the danger zone, often when humidity lingers above that critical 60% mark.
Even better, these systems can take action automatically. IoT-enabled HVAC units and connected vents can respond instantly when moisture spikes, kicking on dehumidifiers or boosting airflow before mold has a chance to grow.
It’s a level of protection that turns an inspection from a once-a-year event into a continuous safeguard.
For homeowners, this tech offers peace of mind. And for inspectors, it means more accurate data and a clearer picture of where problems are brewing.
Either way, it’s a powerful step forward in keeping living spaces healthy, energy-efficient, and mold-free.
The Role of Artificial Intelligence in Mold Detection
AI now brings serious muscle to mold inspections that are becoming more powerful. If we look at the traditional inspections, which heavily rely on the inspector’s judgment and experience.
But AI-based systems can analyze huge amounts of data from moisture levels and air samples to building material profiles and even past inspection records.
Here’s what that means in practice:
- Pattern recognition: What humans might overlook, but AI can detect the subtle signs, such as recurring humidity spikes in specific corners of a building.
- Predictive modeling: Instead of just telling you where mold is now, AI tools can forecast where it’s likely to appear in the future, based on current conditions.
- Enhanced accuracy: By comparing live data to thousands of past cases, AI systems help inspectors confirm whether suspicious readings are truly signs of mold or just normal variations.
In commercial real estate, AI-backed tools are a real WIN. Not to mention that Large office buildings often have complex ventilation systems with multiple zones.
An inspector armed with AI-backed tools can quickly scan the system’s data logs and identify problem areas without needing to open every duct or crawl into every ceiling.
That reduces inspection time and helps facility managers address risks faster, and lets data logs tell the story.
The Future of Mold Inspections
It might not be wrong if we say that mold inspections are no longer limited to sniff tests and DIY kits. Say BYE BYE to them. The industry is shifting toward science-driven methods where accuracy and speed matter most.
What once required drilling into walls or waiting on outside labs can now be handled with fast professional-grade tools, certified sampling techniques, and in-house analysis.
This is exactly how 5 Microns does the inspection. Here, the licensed experts collect detailed air and surface samples, then process them through accredited labs to detect mold at the microscopic level.
The result is faster with more reliable data that reveals not only what’s on the outside, but also hidden growth and airborne spores that could affect the health. As this kind of precise testing becomes the norm, it won’t just be for big commercial sites, but for homes, schools, and everyday community spaces will expect this standard of accuracy and safety too.
Final Thoughts
At the end of the day, mold inspection is not limited to walls and ceilings. But it’s all about the health of the people living or working inside those spaces. Advanced detection helps keep both property and people safe, making it one of the most important steps in building maintenance and indoor health today.
That’s why at 5Microns, we’re committed to pushing the boundaries of what mold detection can do. By combining the latest technology with industry expertise, we help property owners and businesses take action before small problems become major ones. Because a healthier building means a healthier life.

